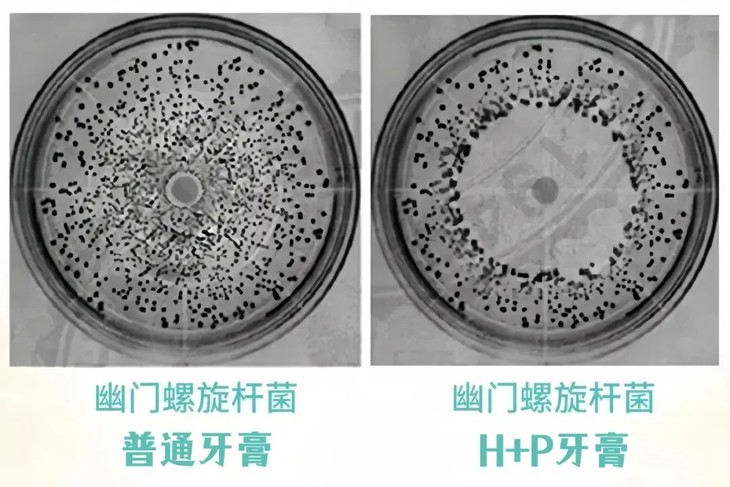

有一种尴尬叫做,口臭而不自知。
很多人只要张嘴说话就散发出恶臭,就算穿的再好,打扮的再精致,形象分立马减到0!

要知道,口臭可不是小事。知名医学杂志《JAMA》就说过,“约90%的口臭,源自口腔细菌。”
突然口臭或者口腔经常有异味,是你的嘴在提醒你啦!一旦严重起来,还会引发牙疼、牙龈出血……简直是苦不堪言。

不止是成年人有口臭的困扰,朋友家8岁的宝宝竟然也有口臭的问题。
不查不知道,一去医院才知道,这是被家里大人传染了幽门螺旋杆菌(HP)。

口腔中的幽门螺杆菌如果不及时铲除,还会进一步感染到胃,在胃里繁殖发酵产生恶臭气体,不断往上涌。
所以无论刷多少次牙,嘴巴里还是会散发臭气!

不仅仅是口臭,诺贝尔医学奖得主马歇尔研究发现:幽门螺旋杆菌(HP)是引发胃炎、溃疡的罪魁祸首,严重的还会引发胃ai!

它的传染性也高的吓人!一人中招,全家遭殃!共同用餐、喂食、亲吻都会传染,要小心!


所以说,要想从根源上解决口臭问题,保持身体健康,祛除幽门螺杆菌(HP)是关键!
最近,小编就被20年老烟民朋友推荐了一款,治标又治本的【Skon速康生物溶菌酶H+P牙膏】。

99.95%抗幽率,从源头清新口气、保护肠胃!
有抑幽效果的专利证明,让国人见识到国货正在迅速崛起!
线下商超、口腔医院同款在售

买过的家人都说“好用”,而且老客户回购率90%!

它不像漱口水那样辣口、清几秒就恢复原样;也不像口香糖那样时效短,让脸变大。
每天用它早晚刷一刷,肉眼可见改善口腔HP。

朋友小程被口臭困扰多年,买来HP测纸一测,果然感染了幽门螺杆菌。

后来试用了这款牙膏后,口气清新了不少,用试纸重新测量了一下,颜色淡的看不出来,几乎没有HP了!

看这前后对比图,太厉害了!不敢相信!

而且每次刷完牙,口臭指数都很低,靠近也不会闻到口臭了,和同事聊天都自信不少!

如果你有口臭烦恼,早上起来口苦口干,平时肠胃不太好的,强烈建议试一下这个牙膏!
相信一定能还你清新口气,社交起来更加自信迷人!

日常京东39.9元/支

今日粉丝福利价79元
一次带走5支100g正装+12支10g小样
相当于到手6支正装+20g
立省160元!
点击图片,立即购买▼
99.9%抗幽率
为全家解“幽”,口气更清新
口腔号称“细菌王国”,它里面含有几十亿的细菌,甚至比马桶还要多。

目前市面上许多的抗幽牙膏,效果没保障,阻抑HP的效果微乎其微,更别说起到抵御作用。
没有抗幽报告的产品,尽量还是不要去碰,选购的时候一定要睁大眼睛看仔细了!

而这款牙膏,不说别的,直接上检测报告,抑菌率为99.95%,不整那些花里胡哨的,效果就是这么顶!

为了更直观地感受效果,我们做了一个实验。
左边是传统牙膏,右边是H+P牙膏,刷牙3分钟后,效果对比明显,口腔内的幽门螺旋杆菌下降很多!
为更好的击败口腔中的细菌,速康加入了核心科技:“生物溶菌酶技术”
简单的来说,“生物溶菌酶”在人体口腔唾液中像一支“口腔隐形护卫队”,默默打退“坏菌”,守护口腔小生态。

坚持刷牙2-3分钟,就能快速抑制幽门螺旋杆菌,从根源改善口气~

嘴巴就像打开清新开关,交谈更自信。

8大植物精粹+益生菌配方
平衡口腔菌落,击退“坏菌”
牙齿每天接触各种食品、饮料无数次,想要从根源消除难闻的口气、改善牙齿光泽度,平衡齿菌是第一步!

而这款牙膏里采用的四联益生菌配方能提升免疫力、让菌体更“听话”,口腔代谢能力得到提升,解决完这一列常见问题。

牙齿基础打好了,整个呼吸都是清新的,烦人的“口腔尴尬”自然一扫而空~

除此之外,还添加了多种中草药植物精粹。
头号成分就是黄连提取物和连翘提取物,一直以来它们都是清热解du的好成分,在我国古代早已得到广泛应用。

此外,还复配了多种草本精萃:薄荷、罗汉果、蜂胶、乳香等提取物,温和不刺激!

像牙菌斑中的“坏菌”牙龈卟啉单胞菌,是龋齿、口气、牙周炎等常见口腔疾病的重要致病菌。

等牙齿出了问题,去医院拍片治疗都得花三四千,还受罪。
早晚用它刷一刷,丰富的小气泡深入渗透牙龈和牙缝深处,赶走各种藏匿病菌。好好刷牙就是省下一笔巨款!

为了让大家看得更明白,小编特意找了与牙齿成分相同的两个鸡蛋,用牙膏刷的鸡蛋洁净无瑕,而普通牙膏的鸡蛋满是污斑!

坚持使用还能帮助改善牙龈红肿、出血等问题,有了它,口腔健康有保障,再也不用担心长溃疡啦~

除此之外,不管烟渍、茶渍、咖啡渍,十几年的老黄垢都能统统搞定 !
我的一个老烟枪朋友, 牙布满烟渍,怎么都拯救不了!没想到用了一段时间,烟渍给溶菌酶溶解了!

口臭改善了,黄牙不见了,自然更有自信了。

温和呵护,不伤牙齿
全家都能用
泡沫多又细腻,不需要太用力,就能把角角落落的“脏东西”都带走。

满满的蜂胶精华,放在嘴里就能感到清爽的薄荷味!

牙齿明显变白净,就连舌苔都滑滑的,特别舒服!
放肆微笑,再也不被嫌弃嘴巴像下水道一样臭了!

经过三方机构检测,各项指标都符合标准,无酒精,无糖精钠,无有害防腐剂,无矿物油

牙膏家家户户都需要,尤其是家里有抵抗力弱、肠胃功能差的老人和小孩!

用它刷刷牙,全家无“幽”,还你健康口腔和肠胃。

大人刷一刷,口气清新,社交自信,工作顺利;肠胃健康,吃嘛嘛香,生活更顺心。
小孩刷一刷,胃口大开不挑食,肠胃吸收好,长个比同龄快,爸妈看了都开心。

普通的牙膏,没有抗幽报告,不建议购买!
其它品牌的抗幽牙膏?随便一搜,这个价格真的是劝退了。

而这款牙膏,主打温和氨基酸配方,加入生物溶菌酶,复配多种植物精萃,预防HP+洁齿+清新口气三效合一!
早晚一刷,口臭好了,肠胃舒服了!价格更是有惊喜!
感谢粉丝一直以来的支持,现福利大放送!
日常39.9元/支,今日粉丝福利价79元,一次带走5支100g正装+12支10g小样,相当于到手6支正装+20g,立省160元!
点击图片,立即购买▼
买5支,给自己、给老公、给父母、给孩子买1支,又健康又实用!
每天用它早晚一刷,轻松告别口气烦恼!口臭没了,打嗝是香香的!口腔溃疡好了,吃嘛嘛香,每天都开心!

